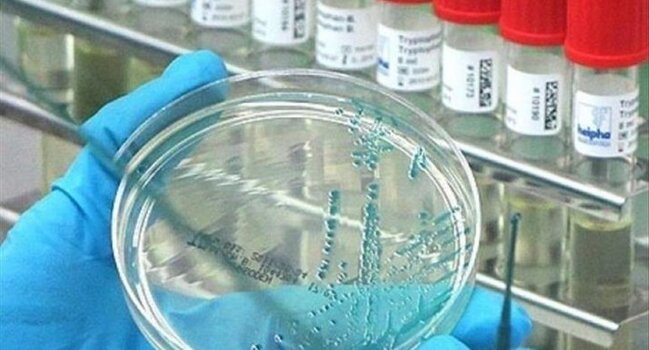
"Beyin yeyən" infeksiya aşkarlandı

"Beyin yeyən" infeksiya aşkarlandı
 Missuri ştatının Səhiyyə və Yüksək Xidmətlər Departamenti yetkin bir insanın nadir ölümcül beyin infeksiyasına səbəb ola bilən "Naegleria fowleri" infeksiyasına yoluxduğunu açıqlayıb.
Missuri ştatının Səhiyyə və Yüksək Xidmətlər Departamenti yetkin bir insanın nadir ölümcül beyin infeksiyasına səbəb ola bilən "Naegleria fowleri" infeksiyasına yoluxduğunu açıqlayıb.
Sonxeber.az Teleqraf-a istinadən xəbər verir ki, infeksiya amebik meningoensefalit və ya PAM adlanır. Xəstəlik "beyin yeyən" infeksiya kimi də tanınır.
Qeyd edilib ki, PAM adətən ABŞ-da ildə 10-dan az insana yoluxur.
İnfeksiyanın mənbəyi hələ də məlum deyil. İlkin məlumatlara görə, xəstənin yoluxmadan bir neçə gün əvvəl Ozarks gölündə su xizəyi sürdüyü məlum olub.
Sonxeber.az
 Telegramda izləyin
Telegramda izləyin
Şikayətiniz varsa Whatsapp: 077 7125666
Facebookda Paylaş
Qəhvə hər kəs üçün uyğun deyil - Ekspert səbəbi izah etdi
Kasnı (çikoriy) ürək döyüntüsü və ritm pozuntusu yaşayan, lakin qəhvədən imtina etmək istəməyənlər üçün alternativ içki hesab olunur. xəbər verir ki, Diyetoloq Natalya Denisovanın sözlərinə görə, gündəlik qəhvə norması dörd fincana qədər olsa da, bəzi insanlar az miqdarda kofeinə belə həssas reaksiy
20 iyunDistant işin psixi sağlamlığa mənfi təsiri açıqlandı
Harvard və Virciniya universitetlərinin tədqiqatçıları müəyyən ediblər ki, uzaqdan iş formatı əməkdaşların psixi vəziyyətinə mənfi təsir göstərir. xəbər verir ki, bu barədə "Science" jurnalında dərc olunan materialda məlumat verilib. Alimlər 500 mindən çox amerikalının sorğu məlumatlarını təhli
6 iyunNiyə insanlar çox yeyir və bununla necə mübarizə aparmaq olar?
Həddindən artıq yemək bir çox insanın gündəlik həyatında qarşılaşdığı problemdir. Mütəxəssislər bildirirlər ki, aclıq hissi insan orqanizminin əsas yaşamaq mexanizmlərindən biri olsa da, müasir dövrdə qida yalnız enerji mənbəyi deyil, həm də emosional və psixoloji ehtiyacların qarşılanma vasitəsinə çevrilib
11 iyunƏn çox allergiyaya səbəb olan giləmeyvələr - Mütəxəssislərdən xəbərdarlıq
Giləmeyvələr sağlam qidalanmanın vacib hissəsi hesab olunsa da, bəzi insanlarda ciddi allergik reaksiyalara səbəb ola bilər. Allergoloqlar bildirirlər ki, xüsusilə çiy halda istehlak olunan bəzi giləmeyvələr immun sisteminin həddindən artıq reaksiyasını tətikləyə bilir. xəbər verir ki, mütəxəssisləri
31 mayKardioloqdan vacib xəbərdarlıq: Bu meyvə ürəyi qoruyur
Ürək sağlamlığını qorumaq istəyənlərə səhər yeməyində avokadodan istifadə etməyi məsləhət görüb. Onun sözlərinə görə, bu meyvə xolesterin səviyyəsinin azalmasına, qan təzyiqinin tənzimlənməsinə və ürək-damar sisteminin daha sağlam fəaliyyət göstərməsinə kömək edir. xəbər verir ki, mütəxəssis bildiri
7 iyunHər gün etdiyiniz səhv ürək xəstəliklərinə səbəb ola bilər
Xörək duzu maddələr mübadiləsinin normal gedişində, sinir və əzələ fəaliyyətində, həmçinin orqanizmdə maye balansının qorunmasında mühüm rol oynayır. xəbər verir ki, həkimlərin sözlərinə görə, yetkin insanların gündəlik minimum duz ehtiyacı təxminən 1,4 qramdır. Tövsiyə olunan gündəlik qəbul miqdar
6 iyun Missuri ştatının Səhiyyə və Yüksək Xidmətlər Departamenti yetkin bir insanın nadir ölümcül beyin infeksiyasına səbəb ola bilən "Naegleria fowleri" infeksiyasına yoluxduğunu açıqlayıb.
Missuri ştatının Səhiyyə və Yüksək Xidmətlər Departamenti yetkin bir insanın nadir ölümcül beyin infeksiyasına səbəb ola bilən "Naegleria fowleri" infeksiyasına yoluxduğunu açıqlayıb. Telegramda izləyin
Telegramda izləyin












 Dəfn müavinəti kimə 600 manat, kimə 3 misli ödənilir? - Vətəndaşların bilməli olduğu QAYDALAR
Dəfn müavinəti kimə 600 manat, kimə 3 misli ödənilir? - Vətəndaşların bilməli olduğu QAYDALAR Əhaliyə XƏBƏRDARLIQ edildi - İyul və avqust aylarında...
Əhaliyə XƏBƏRDARLIQ edildi - İyul və avqust aylarında... Qadınların pensiya yaşı ilə bağlı SON XƏBƏR: İyulun 1-dən etibarən ...
Qadınların pensiya yaşı ilə bağlı SON XƏBƏR: İyulun 1-dən etibarən ... Sosial müavinət və təqaüd alanlarla bağlı ŞAD XƏBƏR
Sosial müavinət və təqaüd alanlarla bağlı ŞAD XƏBƏR Bakıda su PROBLEMİ - Məhdudiyyətin SƏBƏBİ AÇIQLANDI
Bakıda su PROBLEMİ - Məhdudiyyətin SƏBƏBİ AÇIQLANDI Bu tarixdə QISA İŞ GÜNÜ OLACAQ
Bu tarixdə QISA İŞ GÜNÜ OLACAQ Hava KƏSKİN DƏYİŞƏCƏK: Temperatur enəcək - BU TARİXƏDƏK
Hava KƏSKİN DƏYİŞƏCƏK: Temperatur enəcək - BU TARİXƏDƏK Yumurtanın bişirilərkən çatlamasının qarşısını alan 5 sadə üsul
Yumurtanın bişirilərkən çatlamasının qarşısını alan 5 sadə üsul PENSİYA YAŞINDA DƏYİŞİKLİK... - "Bu, yüksək məbləğdə pensiyaya imkan yarada bilər"
PENSİYA YAŞINDA DƏYİŞİKLİK... - "Bu, yüksək məbləğdə pensiyaya imkan yarada bilər" Bakıda suyun kəsilməsi ilə bağlı RƏSMİ AÇIQLAMA
Bakıda suyun kəsilməsi ilə bağlı RƏSMİ AÇIQLAMA Müəllimlər üçün vahid forma, yoxsa dres-kod?
Müəllimlər üçün vahid forma, yoxsa dres-kod? Toy mədəniyyətində dönüş - ŞOK QADAĞA GÜNDƏMDƏ
Toy mədəniyyətində dönüş - ŞOK QADAĞA GÜNDƏMDƏ Ayın 22-də ölkədə qısamüddətli yağış və külək gözlənilir - PROQNOZ
Ayın 22-də ölkədə qısamüddətli yağış və külək gözlənilir - PROQNOZ Şəkidə kəndi su basdı - Sakinlər köçürüləcək
Şəkidə kəndi su basdı - Sakinlər köçürüləcək "WhatsApp" Türkiyədə pullu oldu
"WhatsApp" Türkiyədə pullu oldu